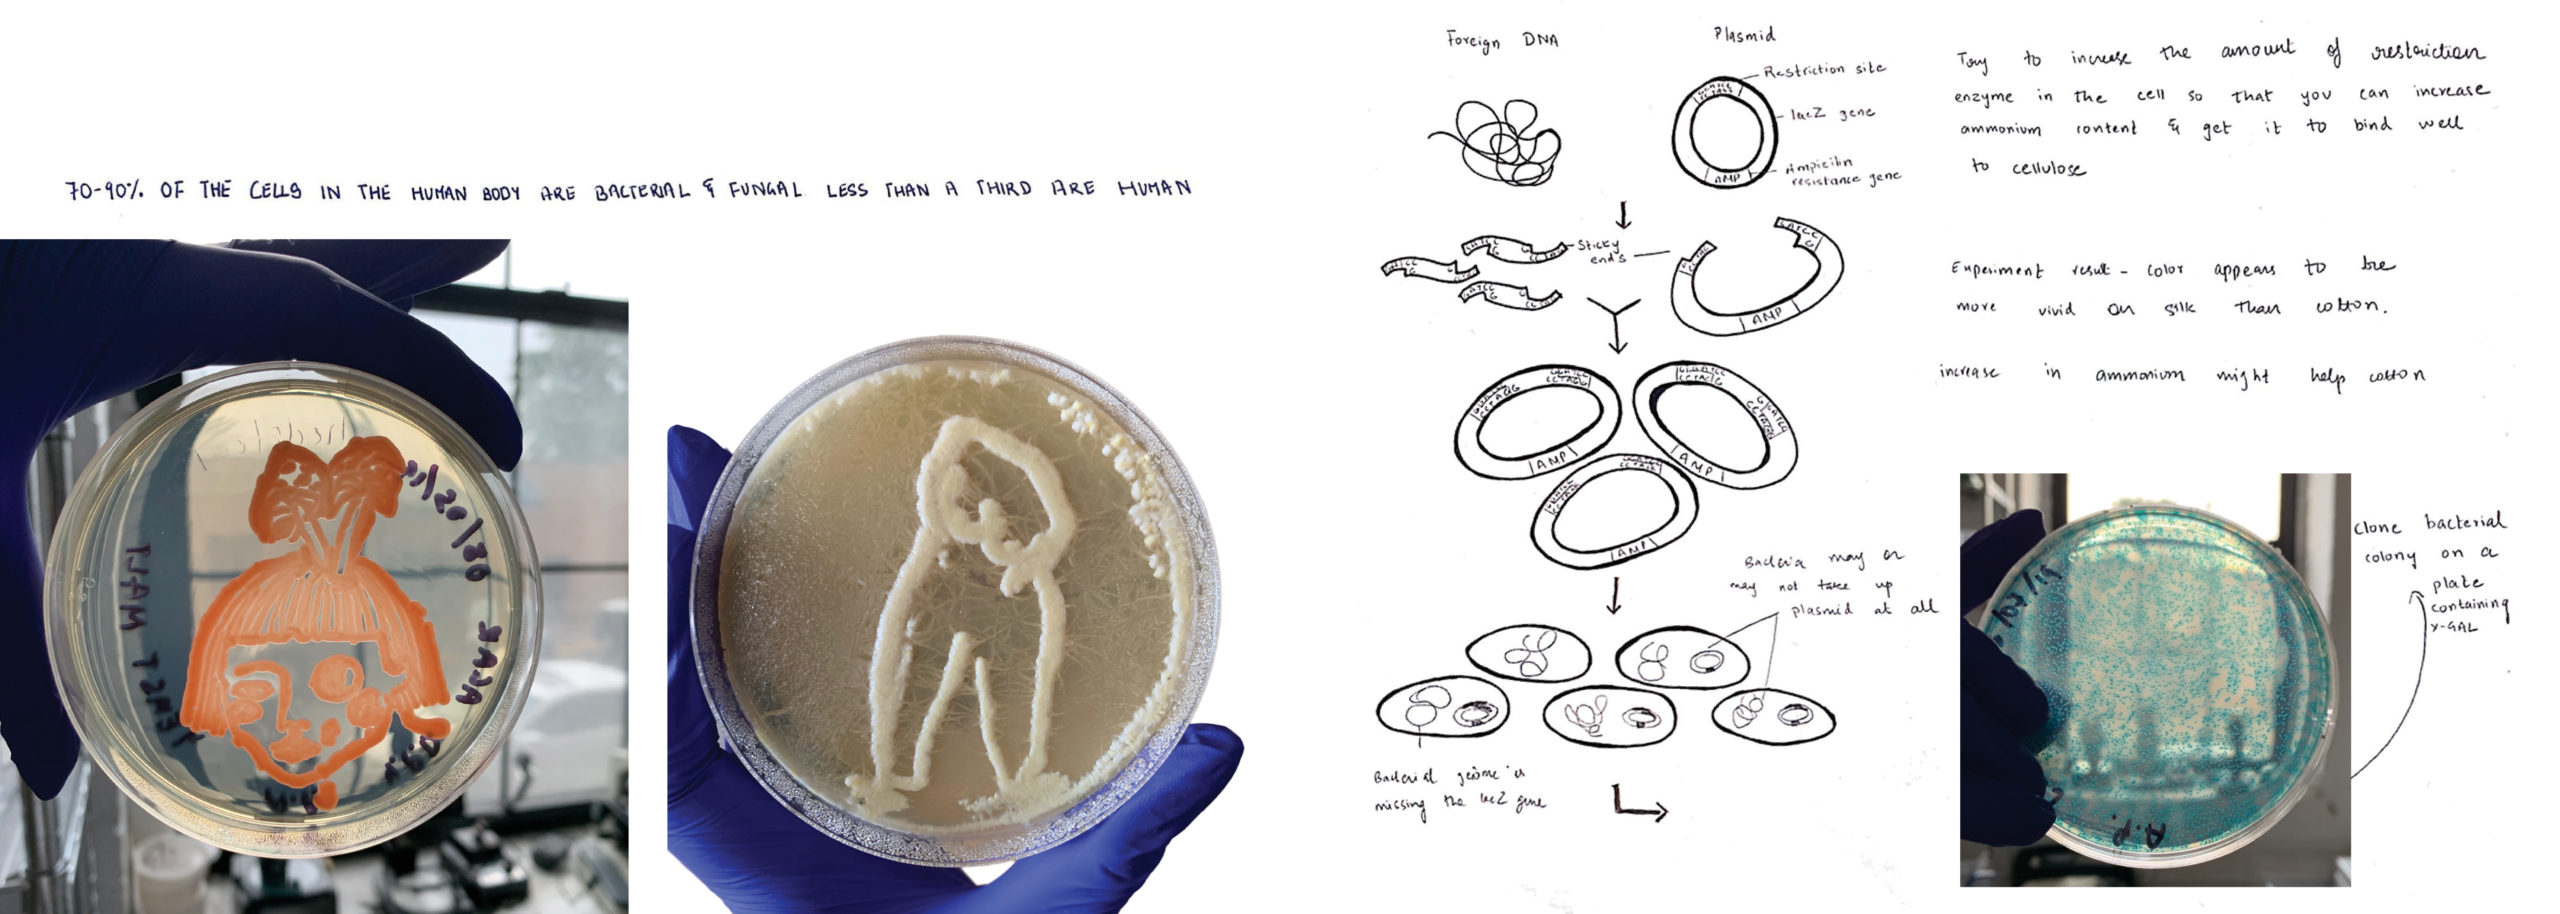
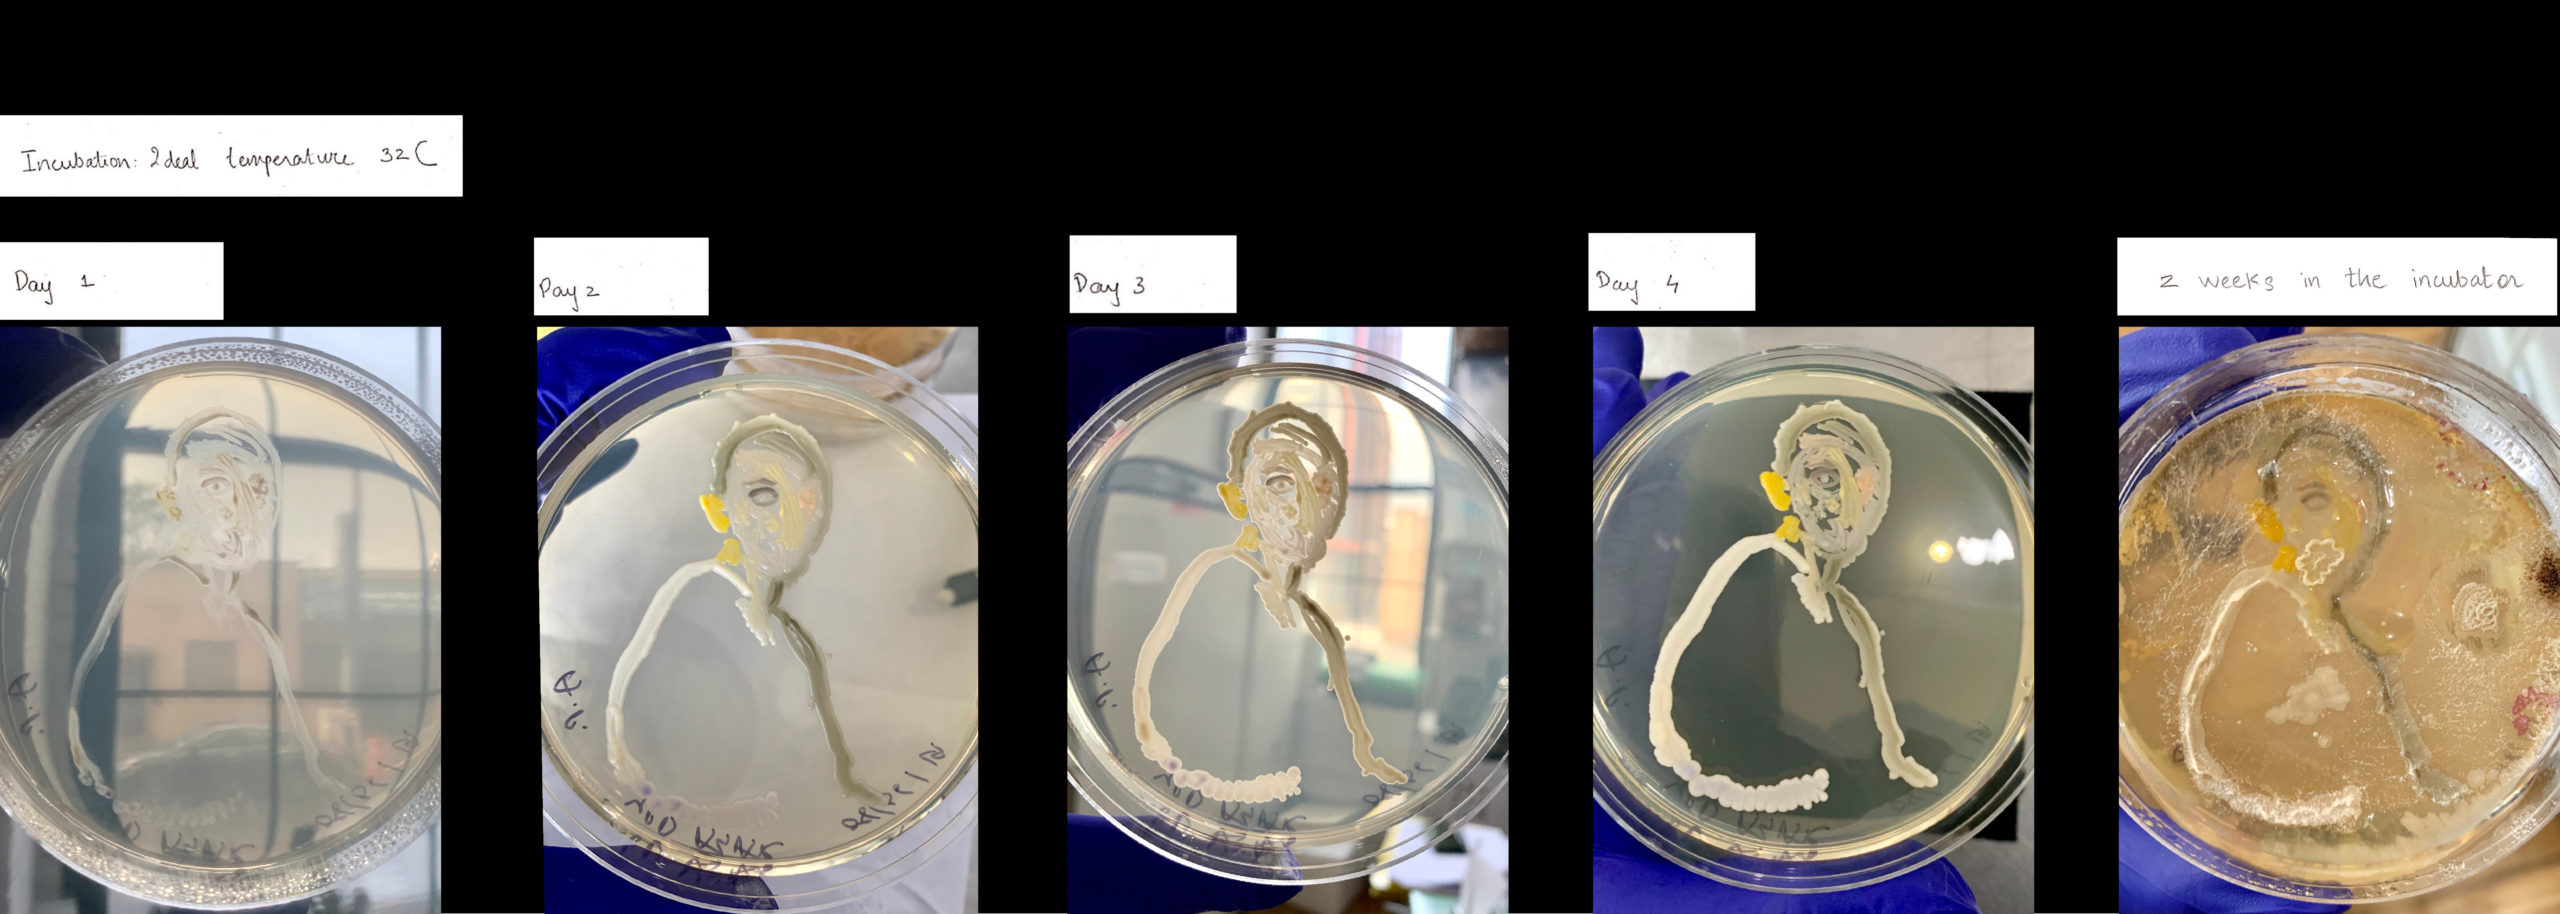

[ 01 ] In an attempt to replace micro plastic I began experimenting with creating beads and sequence from bioplastic. However, I found myself intrigued by the random shapes that bioplastic molded itself into once it dried. I began sewing these pieces onto fabric

[ 02 ] Experiments with bioplastic

[ 03 ] Fabric dyed using genetically modified bacteria. After sterilizing fabric I started placing pieces in various ways to create varying patterns. When satisfied with a pattern I would finally sew it together. However, I wanted the swatches to tell a story and be part of a collection. Often, after completing one swatch I would use it as inspiration for the next.

[ 04 ] Process- Images from the lab
[ 05 ] Ninety-nine percent of the unique genes in the human body are bacterial. Only about one percent is human. What can be more natural than dyeing fabric with competent bacteria? In the lab I have to wear gloves to protect the bacteria from me and not the other way around.
[ 06 ] I found very little information in books or the Internet about dyeing fabric with bacteria or creating art with bacteria. To find the ideal temperature and ideal duration for my bacteria to grow I went to the lab every day to examine the Petri dish. I realized that the bacteria reached its peak on the fourth day after which it starts to dull down. After being left in the incubator for about a week the agar slowly began to grow mould. Bacteria grew brighter quicker on fabric than agar. Results on silk can be seen after a few hours of incubation.

[ 07 ] My aim was to create simple shapes with a focus on movement. I extensively researched Vionnet and Halston and tried to recreate their patterns for inspiration.

[ 08 ] When I first started working in the lab I realized that it took about three days for the bacteria to reach its peak and that the best result could be seen on silk charmeuse. For this fabric swatch, I wanted to visually display what I experienced in the lab. On the first day, a few colonies began to acquire color and after about three days the entire plate begins to display color. The swatch starts out with only a few squares of color and the rest is black. Gradually the intensity of colour increases and so do the number of colored pieces. However, if the Petri dish is left in the incubator for too long the color begins to dull down again and so while draping the swatch I flipped it upside down.

[ 09 ] This fringed dress features bright green circles dyed with E-coli that I genetically modified. Bacterial dye is not only vivid but also colorfast. Black circles are cut out from leftover fabric pieces from past projects and fabric I found in Parsons reuse bin. Whenever I’m making clothes I focus heavily on the garments movement. I wanted to study and photograph the dress in different ways, not just on the human body.

[ 010 ] The last three looks are some of the final pieces from my collection. All colors except black are derived from bacteria. I was working towards creating simple silhouettes that would best feature my textiles.

[ 011 ] This is a close up image from a garment I made using pink swatches dyed with bacteria. I was trying to find creative ways to patch petri dish sized circles to form big fabric pieces. I began to fold the circles to create flower like shapes

[ 012 ] I was very inspired by Josef Albers’s homage to square collection. I began experimenting with reversing the order of the rectangle to see how flipping the sequence of color would impact visual reception

[ 013 ] After working in the lab for a few months I felt comfortable to scale up my process. I dyed two yards of fabric with genetically modified competent E-coli I used 1.5L of water in total for the entire process which is about 431 times less water than the industry average (with synthetic dyes). Scaling up caused the color to be a little lighter than fabric dyed in a petri dish as the fabrics contact with agar reduces

[ 014 ] To create this piece I dyed three yards of silk dyed with E-coli. I really enjoyed patching fabric to create larger forms and wanted to continue experimenting with combining and covering fabric on the larger pieces as well.

[ 015 ] I began to place circles dyed with bacteria, synthetic dyes, and natural dyes derived from plants to create fabric swatches that resembled paintings.